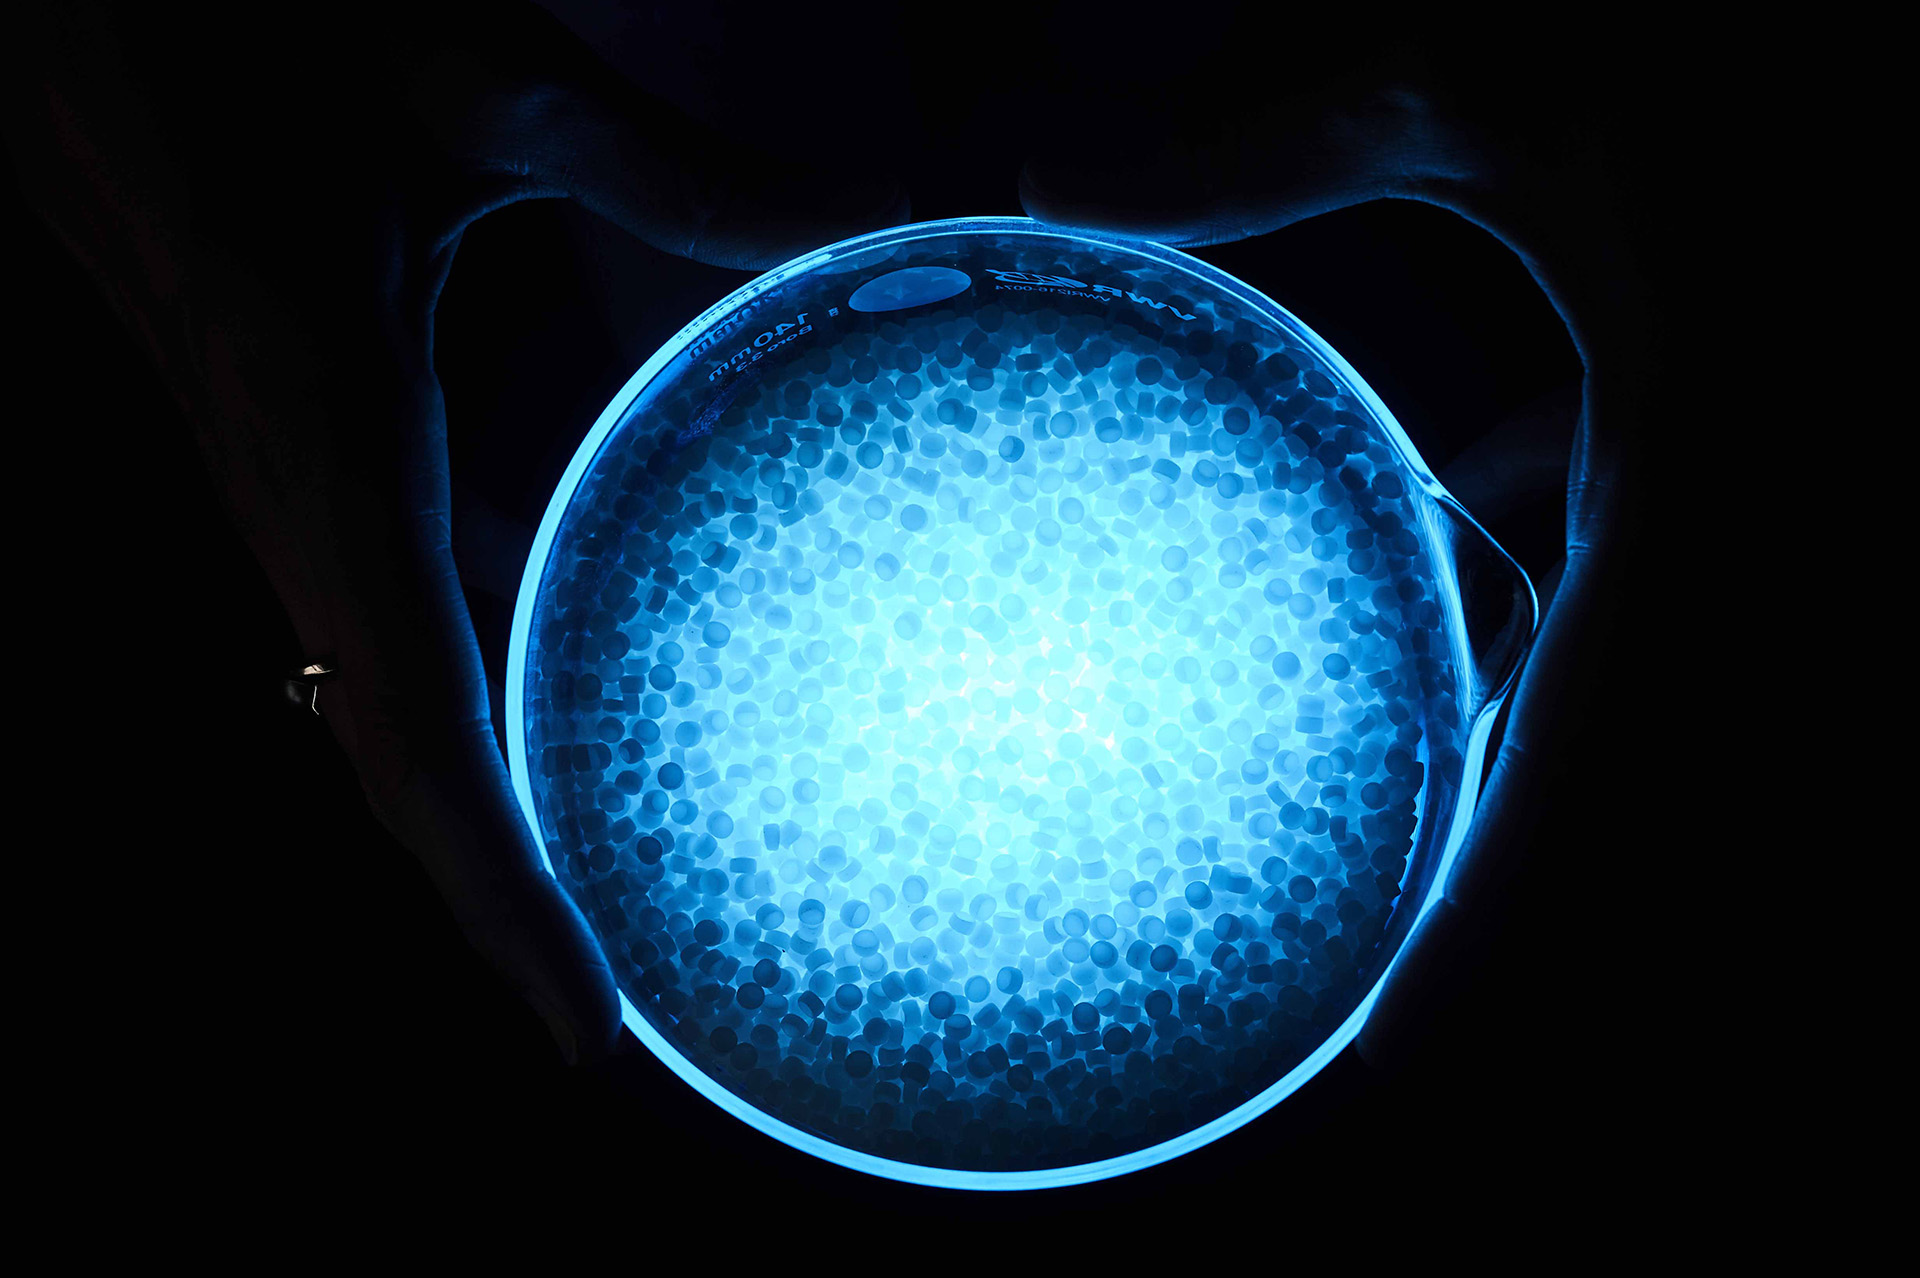
Niebieska sfera na czarnym tle

Wstęp
Table of contents
Europejska Rada ds. Innowacji (EIC – European Innovation Council) to flagowy projekt Komisji Europejskiej z budżetem 10 miliardów euro na lata 2021-27, którego celem jest identyfikacja, rozwój oraz wyskalowanie wschodzących technologii o globalnym potencjalne do komercjalizacji.
EIC wspiera rozwój technologii znajdujących się zarówno na bardzo wczesnym etapie rozwoju, gdzie dopiero formułowane są założenia i czynione pierwsze obserwacje, jak i bardziej dojrzałych pomysłów, które zostały już przetestowane i potrzebują dalszego finansowania, sprawdzającego np. ograniczania czy też ryzyka rynkowe związane z daną technologią.
Jakie technologie wschodzące najlepiej wpisują się w strategię rozwoju Unii Europejskiej?
EIC wskazała trzy obszary zastosowania dla technologii, które mają największe znaczenie ze strategicznego punktu widzenia dla Unii Europejskiej. To „Zielony Ład”, „Zdrowie” oraz „Cyfryzacja i Przemysł”.
1. Zielony Ład
Obejmuje zespół technologii i innowacji o kluczowym znaczeniu dla realizacji założeń Europejskiego Zielonego Ładu, czyli nowej strategii projektowej UE, mającej przekształcić Europę w neutralne klimatycznie, sprawiedliwe i dostatnie społeczeństwo o nowoczesnej, efektywnej oraz zrównoważonej gospodarce. Do najważniejszych obszarów technologicznych można zaliczyć tu:
- pozyskiwanie, przetwarzanie i przechowywanie energii,
- chłodzenie i kriogenikę,
- dekarbonizację rolnictwa i przemysłu oraz ograniczenie zanieczyszczeń,
- a także zrównoważone budownictwo i systemy monitorujące środowisko.
2. Zdrowie
W przypadku obszaru Zdrowia, EIC zidentyfikowana kilkanaście kluczowych technologii, które uskutecznią leczenie i terapię pacjentów. Wśród nich m.in.:
- genetykę kardiologiczną,
- inżynierię tkankową oraz medycynę regeneracyjną opartą na technologiach kosmicznych,
- opracowywanie leków w oparciu o sztuczną inteligencję,
- leczenie nowotworów oraz rzadkich chorób genetycznych z wykorzystaniem RNA,
- terapie genowe i komórkowe,
- biologia syntetyczna do zastosowań przemysłowych.
3. Cyfryzacja i Przemysł
Wśród technologii pozwalających na zaawansowaną cyfryzację i unowocześnienie przemysłu, Europejska Rada ds. Innowacji zwróciła uwagę przede wszystkim na:
- architektury i urządzenia komputerowe nowej generacji, w tym alternatywne podejście do komputerów kwantowych oraz oparte na DNA cyfrowe przechowywanie danych,
- fotonikę,
- materiały 2D przeznaczone dla urządzeń o niskim zużyciu energii,
- opartych na sztucznej inteligencji „lokalnych cyfrowych bliźniaków”, czyli cyfrowe kopie istniejących miast służące do przeprowadzenia symulacji rozwoju konkretnych obszarów miejskich.
Trzy schematy finansowania technologii w zależności od fazy jej rozwoju
EIC dysponuje trzema różnymi schematami finansowania, które odpowiadają różnym stadiom rozwoju opracowywanych technologii, czyli tzw. TRL (ang. Technology Level Readiness – sprawdź czym charakteryzują się poszczególne poziomy TRLOtwiera się w nowej karcie):
- EIC Pathfinder – finansowanie prac badawczych dla technologii znajdujących się w we wczesnej fazie rozwoju (TRL 1-4).
- EIC Transition – finansowanie strategii biznesowej i planów komercjalizacji już sprawdzonych technologii (TRL 4-6).
- EIC Accelerator – finansowanie prac związanych z komercjalizacją i skalowaniem (TRL 5/6-9).
Konkursy EIC na rozwój technologii w 2022 roku
Otwarcie konkursów na finansowanie wyżej wymienionych technologii, a przynajmniej większości z nich, nastąpi w bieżącym roku. Poniżej przedstawiamy listę technologii oraz konkursów (podane w nawiasie) w ramach, których ich rozwój będzie finansowany.
Zielony Ład
- integracja systemów przechowywania energii (EIC Pathfinder);
- integracja technologii produkujących czystą energię w jeden system (EIC Transition),
- zarządzanie dwutlenkiem węgla i wodorem (EIC Pathfinder),
- „Fit for 55”: dekarbonizacja przemysłu ciężkiego, lepsze wykorzystanie i konwersja czystej energii, zero emisyjny transport, neutralność klimatyczna w użytkowaniu ziemi, zarządzanie i systemy monitorowania wody, gazu oraz powietrza wewnątrz pomieszczeń (EIC Accelerator),
- „Open Strategic Autonomy”: obieg zamknięty materiałów o krytycznym znaczeniu dla gospodarki (EIC Accelerator).
Zdrowie
- kardiogenetyka (EIC Patfhinder),
- terapie oparte na RNA oraz diagnostyka rzadkich chorób genetycznych (EIC Transition),
- „Open Strategic Autonomy”: komponenty, technologie i systemy dla przemysłu farmaceutycznego (EIC Challenge),
- technologie skoordynowanej opieki zdrowotnej – Healthcare Continuum (EIC Pathfinder).
Cyfryzacja i przemysł
- przechowywanie danych w oparciu o DNA (EIC Pathfinder),
- „zielone” urządzenia cyfrowe przyszłości (EIC Transition),
- wykorzystanie technologii kwantowych w przetwarzaniu informacji, komunikacji oraz w monitorowaniu (EIC Pathfinder),
- „Fit for 55”: „Zielone technologie cyfrowe” (EIC Accelerator),
- “Open Strategic Autonomy”: technologie kwantowe, technologie kosmiczne, kluczowe technologie związane z bezpieczeństwem (EIC Accelerator).
Jak aplikować?
Do konkursów można aplikować wyłącznie za pośrednictwem platformy internetowej Komisji EuropejskiejOtwiera się w nowej karcie. Najlepiej założyć sobie konto a następnie wyszukiwać informacje o konkursach wchodząc na podstronę jednego z trzech instrumentów wsparcia EIC, a następnie przejść do zakładki "funding opporunities". Nabory, tzw. cut-off prowadzone są kilka razy w roku. Zapoznaj się też z przewodnikiem dla aplikującychOtwiera się w nowej karcie.
Zachęcamy też do kontaktu z Krajowym Punktem Kontaktowym Programów Badawczych UE w celu uzyskania bardziej szczegółowych informacji o konkursach i zasadach uczestnictwa.
Firmy z sektora małych i średnich przedsiębiorstw mogą też ubiegać się o zwrot kosztów przygotowania wniosku w ramach tzw. grantów na eurograntyOtwiera się w nowej karcie, obejmującymi wsparcie finansowe w wysokości do 280 tys. złotych. Przyjmowanie wniosków jest otwarte do 11 sierpnia.
Źródło: Identifacation of Emerging Technologies and Breakthrough Innovation, European Innovation Council.
Opracowanie: Departament Wsparcia Przedsiębiorczości, Enterprise Europe Network












